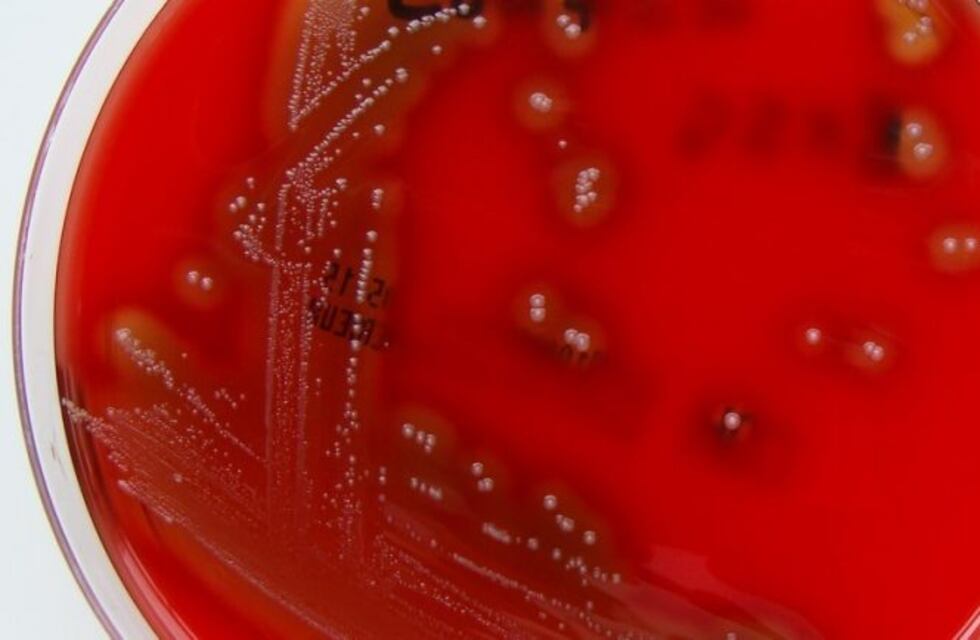
Nuevo caso de Streptoccoco: un chico de 7 años en Santiago del Estero

Un colegio rural de la ciudad de Añayuta -190 kilómetros de la ciudad de Santiago del Estero-, suspendió las clases al detectarse un caso de infección con estreptococo. Este lunes se realizó la desinfección del establecimiento.
En el comunicado que emitió la dirección dice que "la institución se encontrará cerrada en ambos turnos por desinfección".
El viernes pasado, un alumno de 7 años, que asiste a primer grado, sufrió los primeros síntomas del estreptococo e inmediatamente fue asistido en el hospital zonal del lugar. Luego de confirmar mediante resultados de la presencia de la bacteria en el organismo del paciente, se realizó el correspondiente tratamiento.
Los médicos dijeron que el pequeño "se encuentra fuera de peligro, tras ser sometido a una serie de análisis y medicado con antibióticos".
Al respecto, las autoridades de Salud de la provincia explicaron sobre esta bacteria: "Estamos ante una alerta que sirve para que, tanto los médicos como la población, sepan que esta bacteria está circulando, y que las familias deben estar atentas para concurrir al médico ante los primeros síntomas".
Y agregó: "Estos síntomas son: fiebre con temblores, palidez marcada y/o coloración azulada de labios y extremidades, manchas rosadas violáceas en la piel, dificultad para respirar que se incrementa, rechazo de líquidos y alimentos, cuadros confusionales, sueño o irritabilidad excesiva".